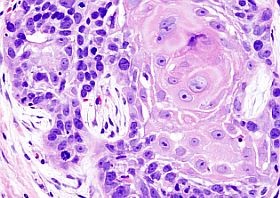
A szőlőmagkivonat rákellenes hatása?

Elpusztítja a rákos sejteket a szőlőmag-kivonat? Csak az Egyesült Államok területén évente mintegy 12 000, míg világszerte több mint félmillió ember hal meg fej-nyaki területet érintő daganatos megbetegedésben. Úgy tűnik, egy lépéssel közelebb kerülünk a megoldáshoz?
Egy új, a Carcinogenesis című tudományos szaklapban múlt héten publikált tanulmány megállapította, hogy a szőlő magjából készült kivonat (GSE) képes elpusztítani a feji és a nyaki területen elburjánzott rákos laphámsejteket, úgy, hogy eközben az egészséges sejtek egyáltalán nem károsodnak.
A szőlőmagkivonat rákellenes hatása?
Forrás: Medipress
"Ez meglehetősen nagy előrelépés a rákkutatásban. A rákos sejtek nagyon gyorsan növekednek és fejlődnek, ám mikor olyan környezetbe kerülnek, amely nem kedvező a számukra, ahol nem képesek a további növekedésre, akkor könnyel elhalnak" - magyarázta Dr. Rajesh Agarwal, a denveri Coloradói Egyetem Rákkutató Központjának tudományos munkatársa és a Skaggs Gyógyszerészeti Centrum professzora.
A szőlőmag-kivonat éppen ilyen feltételeket teremt a rákos sejtek számára, amelyben nem képesek a növekedésre. A tanulmány eredményei szerint a szőlőmagból készült kivonat miközben károsítja a rákos sejtek DNS-ét, egyben meg is gátolja a sejtek gyógyulásának lehetőségét. Ráadásul az egereken végzett kísérletek során semmiféle toxicitást nem lehetett kimutatni (az egészséges sejtekre, szövetekre), hangsúlyozta a kutatás jelentőségét Dr. Agarwal.
A rákos sejtek akkor támadhatók a leghatékonyabban, ha kiiktatják a védekező mechanizmusukat, így ugyanis nem lesznek képesek a regenerálódásra.
A kutatócsoport abban bízik, hogy rövidesen elindulhatnak a GSE hatását felmérő klinikai vizsgálatok, és ennek eredményeképpen megszülethet egy hatékony kiegészítő, ún. másodvonalbeli terápia a fej-nyaki laphámsejtes daganatok kezelésére.
Kövesse az Egészségkalauz cikkeit a Google Hírek-ben, a Facebook-on, az Instagramon vagy a X-en,Tiktok-on is!








